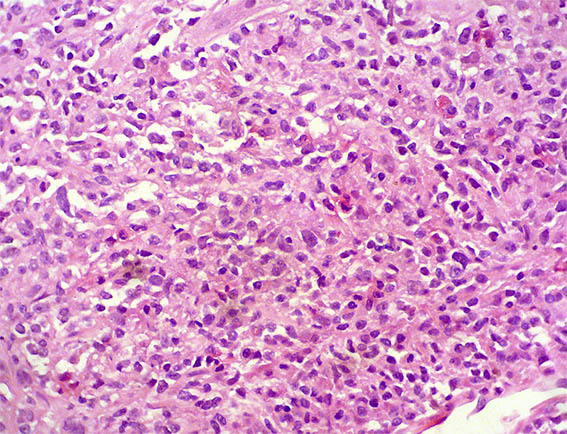
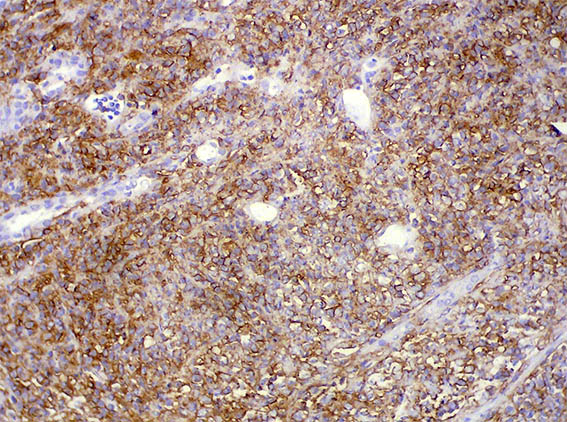
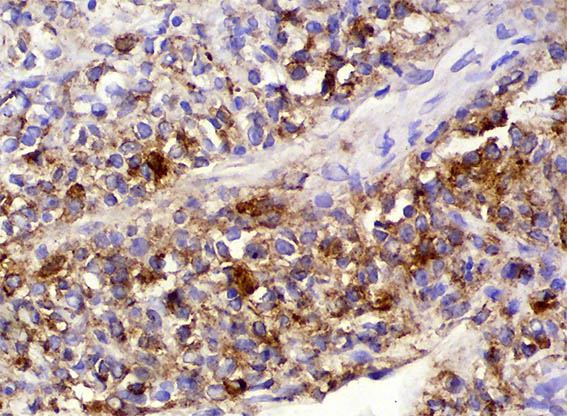

| CASE
116 (October 2015)
Clinical information
The patient is a 36-year-old woman, kidney transplanted 18 months earlier. ESRD of unknown cause. Good graft function until a month earlier when creatinine increased from 1.1 mg/dL to 1.4 mg/dL; now 1.9 mg/dL. No hematuria. Proteinuria 100 mg/dL. No other changes in laboratory tests.
A renal allograft biopsy was done, see the images.

Figure 1. H&E, X40.

Figure 2. H&E, X100.

Figure 3. H&E, X100.

Figure 4. Masson's trichrome stain, X200.

Figure 5. H&E, X200.
Figure 6. H&E, X400.

Figure 7. Masson's trichrome stain, X200.

Figure 8. Methenaime-silver stain, X200.

Figure 9. Immunohistochemistry for CD3, X200.
Figure 10. Immunohistochemistry for CD20, X200.
Figure 11. Immunohistochemistry for LMP-1 (Epstein-Barr), X400.
Immunohistochemistry for SV40 and C4d: Negative.
What is your diagnosis?
See
diagnosis and discussion
[Top]
|